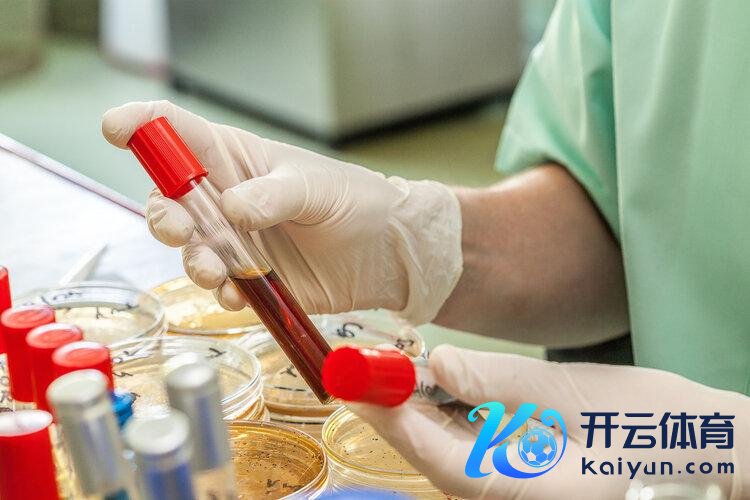

万博manbext网站登录app官网但跟着医学盘考的深切-万博manbext网站登录 万博manbext体育官网注册账号入口

李先生本年56岁,还没比及退休,未必却先一步到来。由于突发中风,在病院里躺了好几天,幸亏救治实时万博manbext网站登录app官网,莫得落下后遗症。
入院本事他闲来无事刷视频的本事,看到有博主科普血型的机要,外传不错估量中风风险,况兼a型血的东说念主发生中风率最高。
这不就巧了吗,我方等于a型血,难说念血型的确有估量疾病的作用?

咱们皆知说念血型是先天遗传的成果,是亲缘关系的基本识别身分。但跟着医学盘考的深切,血型和健康的关系徐徐受到科学家喜欢,况兼越来越多盘考发现不同血型,或能影响不同疾病的发生风险。
一、你会得什么病,血型早就告诉你了?
当代盘考发现,不同血型之间可能赋存健康各异,甚而可能开辟着某些疾病发生的概率。
好意思国马里兰大学医学院就曾作念过这样一项迫临分析,盘考员拜访了1.7万中风患者和60万平方东说念主数据,发现A型血的东说念主早发中风概率更高,盘考东说念主员露出这可能与其凝血因子关联,导致患者更容易发生。

跟着盘考的束缚深切,科学家又发现血型可能和的出现存着说念不解的讨论。
好意思国曾有盘考发现ABO血型与的高关联性,合计ABO位点的DNA序列变异也增多了胰腺癌的易理性。
随后,我国也不时开展了关联拜访,1986年运转长达20年的随访调研拉开序幕,上海地区的18000多名志愿者中A型、B型、AB型、O型比例分辩为31%、27%、10%、32%。本事根据癌症发病情况,发现A型血出现消化系统肿瘤风险最高。
无专有偶,一项捏续了60年,针对10万+不同癌症类型患者的盘考发现,A型血出现癌症风险的比例的其他血型的1.12倍,可能看到这里人人会神往,为什么A型血患癌率这样高?
当今针对这种情况主要存在三种臆度:
一是A血型中捎带的A抗原长的和某些肿瘤的抗原很像,导致免疫系统关于这种抗原掉以轻心。
二是这种血型的东说念主炎症因子粘附力更强,孕育了肿瘤发发生几率。
三是A血型的抗原更容易导致红细胞名义糖基动荡酶失活,细胞之间无法平方讨论,影响细胞生成和凋一火的智力,从而增多了癌症发生风险。
需要指示的是,东说念主的寿命瑕瑜、癌症的发病不只是血型这单并立分决定,影响罹身分有许多,上述盘考也只是给了新的参考,与其烦恼血型,不如早早养成追究的糊口民风,作念好防癌使命,才是健康长命硬意思。

二、血型寿定名次榜,第又名令东说念主未必!
据不完全统计,我国A型、B型、AB型、O型血占比分辩为28%、24%、7%和41%,那么哪种东说念主最长命?血型和寿命间的确有讨论吗?好意思国曾作念过关联盘考,过程800多东说念主的拜访发现,不同血型的东说念主寿命照实会存在各异。
第四:A型血,平均预期寿命60-65岁
盘考合计这可能和其中含有的A抗原关联,这种抗原自身比拟鸠拙,当血液受影响时不会随即反馈,导致这种血型的东说念主免疫力也会比拟差。医学家也发现A型血的东说念主血液茁壮度更高,出现心脑血管疾病风险当然更大。

第三:AB型血,平均预期寿命约68-70岁
固然有了B型血的兼容性,让AB血型的东说念主血液茁壮度低了一些,但仍是要驻扎饮食影响,不然仍是会增多血液茁壮度,增多疾病风险,从而影响寿命。
第二:B型血,平均预期寿命为70-77岁
B型血比起上述两种血型,无论是免疫如故代谢方面皆有更好的阐扬,是以血管更不易受影响,但这种血型的东说念主因为钙质继承可能比拟不及,是以出现骨质疏松的风险也很高,但全体来说健康情状比拟好。

第一:O型血,平均预期寿命为80-85岁
O型血的长命概率是最高的,可能和其兼容A型和B型血上风,加上这种血型的东说念主性情方面也更坚强关联。
尽管O型血更容易长命,但寿命的影响身分不只是由血型决定,况兼多个盘考也发现了O型血的东说念主出现某些疾病风险也很高。
当今还莫得实足凭证标明某一血型不错决定寿命更长或更短,寿命瑕瑜受遗传、糊口民风、外皮环境、以及社会经济等多种要素轮廓影响,因此不是说哪种血型的东说念主就一定能长命。

三、电视剧里的“滴血认亲”靠谱吗?
许多古装电视剧中波及认亲桥段总会出现滴血步调,合计两边血液相融等于有血统关系,这事靠谱吗?
骨子上这个步调只可阐发两东说念主的血型交流,至于有莫得血统关系就两说了。
此外还有东说念主说O型血是全能血,不错给不同血型的东说念主输血,其实这种说法亦然单方面的,医学上关于O型血的使用特别严慎,因为O型血也不是完全莫得输血风险,是以不要神化任何血型。

况兼血型也不见得等于十足不会变化的,有些东说念主跟着骨髓经受移植后也可能发生血型转变,当今咱们关于血型的了解还不完全,期待异日有更多盘考揭秘血型作用。
